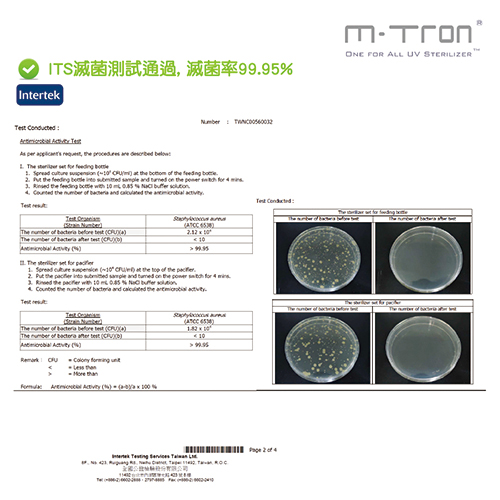

Home > Baby Essentials > Baby care appliances, Furniture > Disinfection, Drying Machine > M-TRON 攜帶型多功能紫外線消毒器



1 / 1
M-TRON 攜帶型多功能紫外線消毒器
奶瓶和奶嘴可同時消毒,亦適用安撫奶嘴、手指牙膠等...
適用於任何標準或寬口徑奶瓶
安全鎖扣設計 / 低功耗 / 智慧安全開關機制
消毒僅需4分鐘,99.9%殺菌
可使用AAA電池 (2顆)或USB
材質:聚丙烯(PP)材質、矽膠(Silicone) 材質
重量:500g
尺寸:長10CM X 寬 10CM X 高 10CM
電源:DC3V AAA X2(顆)、Mini USB input 100-240V
產地:台灣







M-TRON 攜帶型多功能紫外線消毒器
奶瓶和奶嘴可同時消毒,亦適用安撫奶嘴、手指牙膠等...
適用於任何標準或寬口徑奶瓶
安全鎖扣設計 / 低功耗 / 智慧安全開關機制
消毒僅需4分鐘,99.9%殺菌
可使用AAA電池 (2顆)或USB
材質:聚丙烯(PP)材質、矽膠(Silicone) 材質
重量:500g
尺寸:長10CM X 寬 10CM X 高 10CM
電源:DC3V AAA X2(顆)、Mini USB input 100-240V
產地:台灣